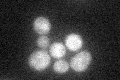
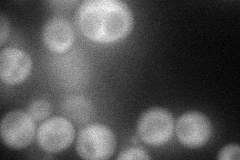
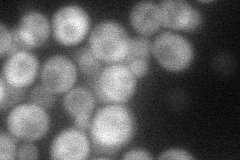
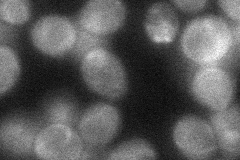
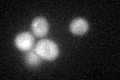

View description
Protein proposed to regulate the endocytosis of plasma membrane proteins; interacts with the cyclin Pcl7p and ubiquitin ligase Rsp5p; phosphorylated by the cyclin-CDK complex, Pcl7p-Pho85p; mRNA is cell cycle regulated, peaking in M phase
Localization:
Intensity:
Fold change:
Significance:
-
C’ GFP library in SD
cytosol28.89 -
N' NOP1pr-GFP in SD
cytosol51.9269 -
N' TEF2pr-mCherry in SD
cytosol39.7605 -
N' NATIVEpr-GFP in SD

below threshold21.0873 -
N' TEF2pr-VC and Cyto-VN in SD
cytosol39.001 -
C’ GFP library in SD+DTT
cytosol30.881.06No -
C’ GFP library in SD+H2O2

cytosol33.991.17No -
C’ GFP library in Starvation Media

cytosol29.671.02No -
C’ GFP library on the background of Pup2-DaMP

cytosol -
C’ GFP library on the background of CCT mutant

cytosol34.25161.18548No
